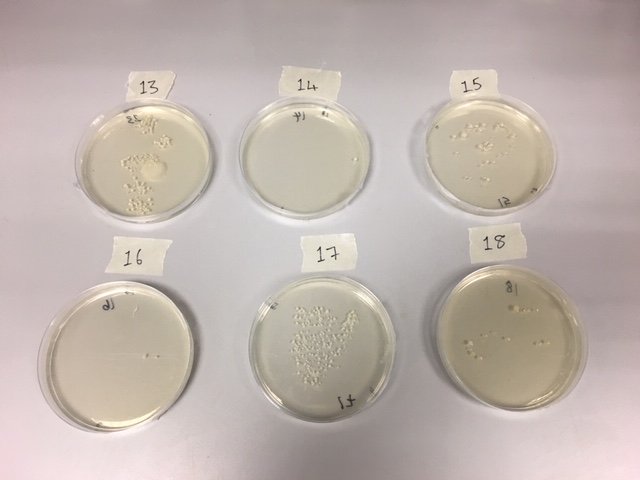
Did you attend the #uoyopenday on Saturday and see what bacteria was growing on your hands? Here are the results! 🦠🔬🧫 #biologyatyork #microbiology 
We'll be sharing the results of Sunday's very soon...
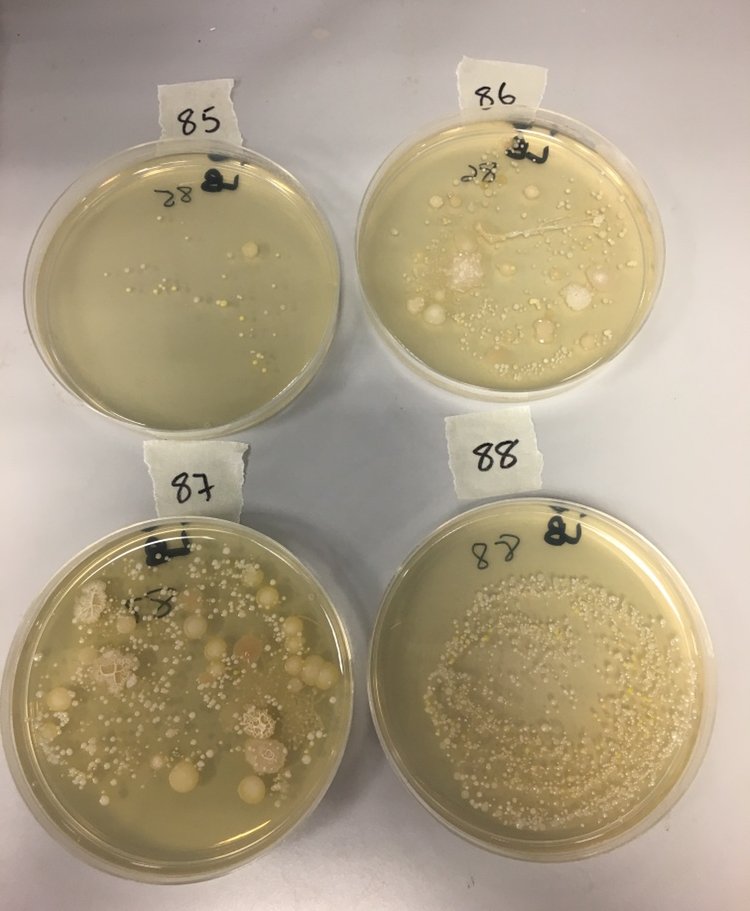
Did you attend the #uoyopenday on Sunday and see what bacteria was growing on your hands? Here are the results! 🦠🔬🧫 #biologyatyork #microbiology
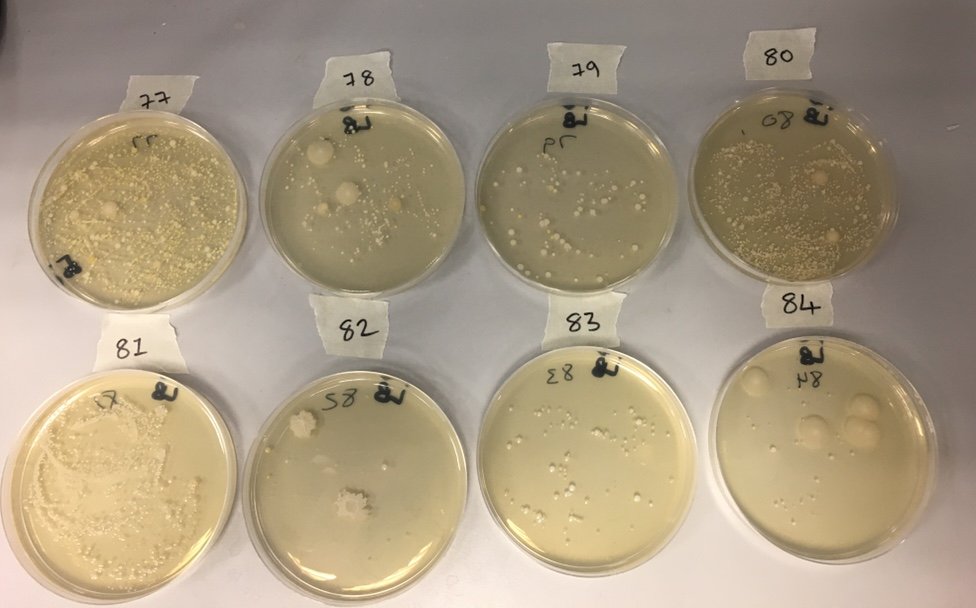
More hand bacteria results from Sunday's #uniopenday #biologyatyork #microbiology

Evie Farnham
@evief14
Final year PhD student @UniOfYork. Interested in genomics, evolution and plant pathogens
ID: 1145260240306356224
30-06-2019 09:18:13
33 Tweet
93 Followers
86 Following




Straight into the business! Yes Biotech 2019 first talk is about IP! I think we are on our way to success! Evie Farnham James Forsythe #YES19


Having fun at #YES19 with a tour of Syngenta and our business pitch is getting there... I think. Martina Stoycheva James Forsythe YES (Your Entrepreneurs Scheme) Syngenta UK #EmpoweringSustainability


And we are off, after two days of hard work the presentation are underway. Good luck everyone 🍀 YES (Your Entrepreneurs Scheme) Syngenta UK #YES19 #EmpoweringSustainability


So proud of my Diesel DeBug team, pitching our idea for investment at #YES19. Martina Stoycheva James Forsythe Syngenta UK #EmpoweringSustainability



Second #M62Microbes meeting today from York's Michael Bottery @MBottery (on interspecies protection in CF-associated bacterial communities) and PhD students Martina Stoycheva Martina Stoycheva and Evie Farnham (on phenotypic diversity in the plant pathogen Ralstonia solanacearum).







It’s been a pleasure to organise the event, even though it sadly ended up online. Thank you very much to all the DTP reps including Evie Farnham Roz Latham Alex Scott Victoria Hill Karolina Pyrzanowska Katie Gelder


Had a great time at the Biology at York graduate symposium yesterday. Lots of great talks and posters!